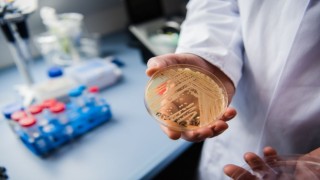
Ölümcül mantarla, yapay zeka desteği ile mücadele edilecek

IRENEC 2023 13’ÜNCÜ ULUSLARARASI %100 YENİLENEBİLİR ENERJİ KONFERANSI, “YEREL ENERJİ KARAR DESTEK ARAÇLARIYLA 2030’A KADAR 100 İKLİM-NÖTR VE AKILLI ŞEHİR” BAŞLIĞIYLA 4 MAYIS’TA BAŞLIYOR.
IRENEC 2023 13’üncü Uluslararası Yüzde 100 Yenilenebilir Enerji Konferansı, “Yerel Enerji Karar Destek Araçlarıyla 2030’a kadar 100 İklim-Nötr ve Akıllı Şehir” başlığıyla 4 Mayıs’ta başlıyor. IRENEC 2023’ün ana temasını, mevcut enerji ağını gelecekte tümüyle yüzde 100 yenilenebilir enerjiye dönüştürme yönündeki küresel hedef oluşturuyor.
IRENEC 2023, Türkiye Yenilenebilir Enerjisi Birliği, EUROSOLAR Türkiye tarafından organize edilen ve pek çok ulusal ve uluslararası organizasyon tarafından desteklenen 13’üncü Uluslararası Yüzde 100 Yenilenebilir Enerji Konferansı 4 - 6 Mayıs tarihlerinde İstanbul Beykent Üniversitesi Ayazağa Yerleşkesinde düzenlenecek.
Avrupa Yenilenebilir Enerjiler Birliği (EUROSOLAR) Türkiye Başkanı, İstanbul Beykent Üniversitesi Öğr. Üyesi Prof. Dr. Tanay Sıdkı Uyar, Rektör Prof. Dr. Volkan Öngel, T.C. Çevre, Şehircilik ve İklim Değişikliği Bakanlığı, İklim Değişikliği Başkanlığı Başkan Yrd. Dr. Tuğba Dinçbaş, Dünya Rüzgâr Enerjisi Birliği Genel Sekreteri Stefan Gsanger, EUROSOLAR Başkanı Prof. Peter Droege, Bodrum Belediye Başkanı Ahmet Aras ve birçok isim konferansta konuşmacı olarak yer alacak.
Konferans, “Yenilenebilir Enerji Entegrasyonu, Avrupa Yeşil Anlaşması, Enerji Dönüşümü 2050, Yenilenebilir Enerji Teknolojileri ve Uygulamaları” olarak 4 ana başlıkta düzenlenecek.

Yorum Yazın